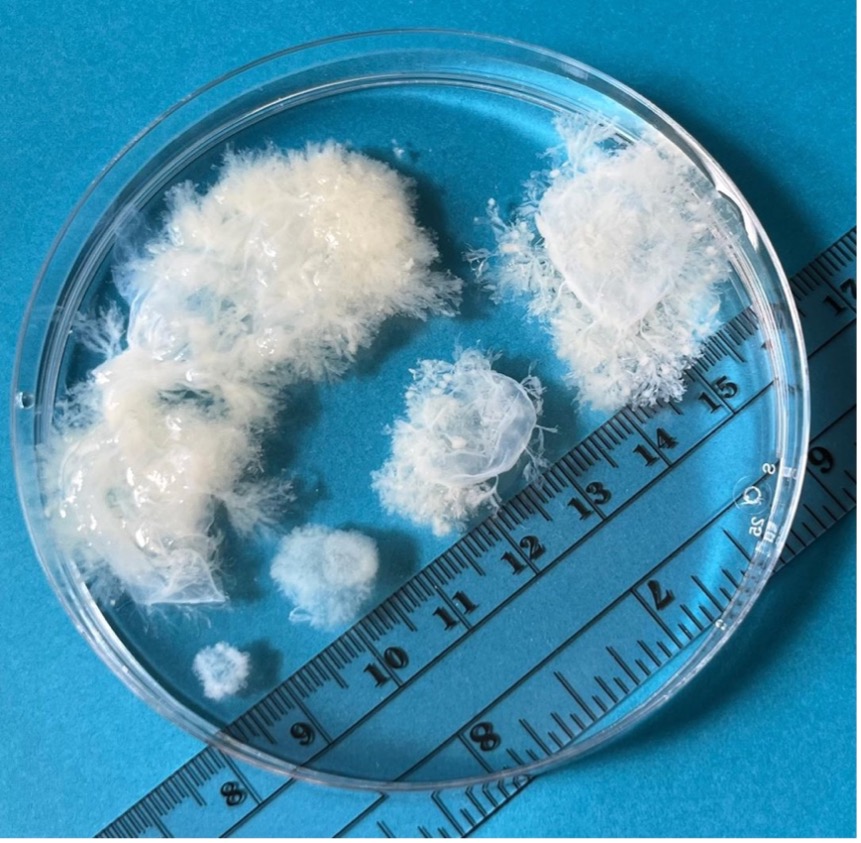

I quite enjoy designing syllabi (and teaching them, of course!). In a perfect world, these are the courses I’d love to teach. I enjoy adaptable assignments and having students engage with place and space as reflective processes of learning. A lot of my course designs asks them to also think about activism as a combination of theorization and praxis. I’ve have the chance to work in curricular design, so the syllabi are mindful of adapting to the changing post-secondary educational landscape and the creep of AI.
*Please Note: The reading lists are comprehensive and only represent potential content I might include, depending on institutional practices and learners’ levels and needs.
english literature, creative writing, & intro critical reading and writing

Course Description
This is an introductory course to reading poetry, prose fiction, nonfiction essays, and the basic principles of writing in a university context. Through reading, students will learn a variety of skills and techniques for writing well-developed, well-organized university-level essays in literary studies.
Required Texts
- Essays and literary texts for each week are listed below. They are available either through the library, through open-access, or will be posted online.
Assignments in the Course
To demonstrate your engagement in the course, knowledge of the material, and proficiency in the skills taught during the term, you will complete various assignments building toward your final creative project. Each assignment type is described below. Please pay close attention to due dates.
Grade Distribution
Weekly Reading Quizzes 10%
Summary Assignment 5%
Midterm In-Class Exam 10%
Final Paper 30%
- Proposal for final paper & annotated bibliography (5%)
- Draft and peer-review (5%)
- Final Revised Paper and Reflection (20%)
Final Exam 30%
Attendance & Class Participation 15%
Weekly Reading Quizzes 10%
There will be weekly reading quizzes to complete online with the intention of helping students stay on-track with the readings.
Summary Assignment 5%
Knowing how to summarize comes in handy, but even more important for students is knowing the difference between summary and interpretation. Since summary is a great skill to have, students will practice effective summary in a short 250-word assignment.
Midterm In-class Exam 10%
The midterm exam will consist of multiple choice and short answer questions to gauge your knowledge retention in the course—do you remember who said what? And when? Why might this matter? A portion of the exam will be about rote memory, while the remainder will be about students’ engagement with course themes and representational strategies covered so far in the course in passage identification and analysis.
Final Paper 30%
Proposal for the Final & Annotated Bibliography (5%)
- Planning ahead and getting early feedback helps students learn important executive-function skills. Students will submit an MLA formatted proposal and annotated bibliography on the topic they would like to write on for the final essay.
Draft of the Final Paper & Peer-Review (5%)
- This assignment gives students the opportunity to work through the revision process and see the writing their peers are doing. Having an early draft of the final paper demonstrates the importance of planning, editing, revising, and proofreading. Peer-review allows students to practice reading critically to provide feedback alongside learning about the importance of receiving and utilizing feedback generally.
Final Revised Submission and Reflection (20%)
- A culmination of working through the proposal, annotated bibliography, drafting, and peer-review, the final paper will demonstrate the majority of the critical reading and writing skills students have been learning throughout the course. This submission should be revised using the feedback from the proposal and peer-review to improve the overall argument of the paper. A one-page reflection will accompany the final submission and discuss how the student implemented the feedback into their revisions.
Final Exam 30%
The final exam will be in three parts. Part one will be literary definitions and multiple choice. Part two will be passage identification and analysis. Part three will be a short comparative essay on major themes or contexts discussed throughout the semester with a focus on three (3) texts.
Attendance & Class Participation 15%
Participation marks depend on the student’s attendance but also their engagement in class. On the first day, we will collaborative draw up an agreement for what “counts” as participation. This might include contributing to class discussion and group work, or other forms of participation that adapt to the students’ learning needs and abilities.
Course Schedule
Week 1 – Getting to Know the Course
- Kain, “How to Do a Close Reading”
- Knott, “Critical Reading”
- Weekly Reading Quiz
Week 2 – Close and Critical Reading
- Freire, “The Importance of the Act of Reading”
- Klinkenborg, “Several Short Sentences About Writing”
- Weekly Reading Quiz
Week 3 – Close and Critical Reading cont’d
- Atwood, “We Are Double-Plus Unfree”
- Weekly Reading Quiz
Week 4 – Gathering Information and Summarizing
- Woolf, “Shakespeare’s Sister” (excerpt from A Room of One’s Own)
- Woolf, “An Unwritten Novel”
- Due: Summary Assignment
Week 5 – What IS a Thesis?
- hooks, “Feminist Politics: Where We Stand”
- Sanders, “The Men We Carry in Our Minds”
- Weekly Reading Quiz
Week 6 – Looking for Evidence
- Laurence “The Loons”
- Alexis “The Night Piece”
- Weekly Reading Quiz
Week 7 – Avoiding Fallacies
- Fisher, “Good for Nothing”
- Weekly Reading Quiz
- In-class Midterm Exam
Week 8 – The Art of Persuasion
- Vonnegut, “How to Write with Style”
- Stenson, “In Search of a Modest Proposal”
- Weekly Reading Quiz
Week 9 – Working with Poetry
- Kaur, poems from Milk and Honey
- Désil, poems from eat salt | gaze at the ocean
- Weekly Reading Quiz
- Due: Proposal & Annotated Bibliography
Week 10 – Expanding Our Ideas
- Chariandy, excerpts from I’ve Been Meaning to Tell You
- Weekly Reading Quiz
Week 11 – The Moves Academics Make
- Graff and Birkenstein, excerpts from They Say / I Say
- Weekly Reading Quiz
- Due: Draft & Peer-Review
Week 12 – Revising and Proofreading
- Readings from “Ask Dr. Editor”
- Weekly Reading Quiz
Week 13 – Review
- Due: Final Essay
First Year Critical Reading & Writing Course

Course Description
We live in troubled and troubling times. Often literature captures that trouble in the form of difficulty, whether someone or something is difficult or we ourselves experience something with difficulty. But in confronting the difficult we can learn to work with the difficult to expand understandings of the world and how to sit with and work through what is experienced as troubled and troubling. In this section of ENGL 110, we will read work that challenges our senses of self-understanding and of belonging in the contemporary world. How and what do we learn from texts that resist easy interpretation, or that articulate a staunch refusal to accept the terms and conditions of their given place? By encountering the difficult we will begin to think through the imperatives offered by unsettling, resistant, resilient, troubling art.
Students should be cautioned that the works on this course syllabus confront sexual violence, misogyny, racism, settler colonialism, national and class prejudice, suicidal ideation, and other troubling—and very real—issues; you should be prepared to be challenged and disturbed by what you read and witness.
Required Texts
- Catherynne Valente, The Past Is Red
- Phillip K. Dick, Do Androids Dream of Electric Sheep?
- Essays and literary texts for each week are listed below. They are available either through the library, through open-access, or will be posted online.
Assignments in the Course
To demonstrate your engagement in the course, knowledge of the material, and proficiency in the skills taught during the term, you will complete various assignments building toward your final creative project. Each assignment type is described below. Please pay close attention to due dates.
Grade Distribution
Critical Reflections 15%
Midterm Essay 10%
Proposal 5%
Final Project 25%
Final exam 30%
Attendance & Class Participation 15%
Critical Reflections – 15%
These reflections can be about personal experience, questions, concerns, or how the week’s readings capture an aspect of “difficulty.” However, the writing must provide at least one citation (quote, summary, or paraphrase) to anchor the ideas. Answers should be specific and detailed, even if they are not fully formed thoughts. Each reflection should be no more than one (1) page, double spaced.
Midterm Essay 10%
The midterm essay will be a focused 1000-word essay on the topic of difficult and one (1) reading we’ve done so far in the course. No additional research is required.
Proposal 5%
This assignment will give students a chance to think about what they would like to do for their final project. The final project may be an essay, artwork, archive, a photo journal, scrapbook, illustration, podcast, vlog, op-ed, creative non-fiction essay, or any other type of project that focuses on some aspect of difficulty discussed in the course. Creative projects must be accompanied by a critical introduction. Students are encouraged to discuss their ideas with the instructor before submitting the proposal. The proposal should demonstrate how the project will critically engage with the course’s materials and theme of difficulty.
Final Project 25%
This project gives students a chance to respond to the course’s content in a variety of ways. Essays should be 1250 words in length with a works cited. Creative projects should have a one (1) to two (2) page critical introduction that cites material from the course and includes a reflection on what difficulty means to the student and as a boarder topic.
Final Exam 30%
Part one will be passage identification and analysis. Part two will be a longer comparative essay on difficulty or trouble and engage in three (3) texts covered in the course.
Attendance & Class Participation 15%
Participation marks depend on the student’s attendance but also their engagement in class. On the first day, we will collaborative draw up an agreement for what “counts” as participation. This might include contributing to class discussion and group work, or other forms of participation that adapt to the students’ learning needs and abilities.
Course Schedule
Week 1 – Getting to Know the Course
- Course Syllabus and welcome materials
Week 2 – What is difficulty?
- Due: Critical Reflection #1
- Steiner, “On Difficulty”
- Haraway, excerpts from Making Trouble
Week 3 – Finding Place
- Due: Critical Reflection #2
- Tiptree Jr, “The Girl Who Was Plugged In”
Week 4 – Working with Metaphors
- Due: Critical Reflection #3
- Rich, poems from Poems: Selected and New: 1950-1974
Week 5 – Doing Homework
- Due: Critical Reflection #4
- Lefebvre, “It’s Not My Job to Teach You about Indigenous People”
- King, “A Coyote Columbus Story”
- Ferguson, “This Story Is Against Resilience, Supports Screaming as Needed”
Week 6 – Perception
- Due:Critical Reflection #5
- Williams, “The Cameras on Your Phones Make Black People Invisible”
- Hopkinson, “Inselberg”
Week 7 – What IS Human?
- Due: Midterm Essay
- Dick, Do Androids Dream of Electric Sheep?
Week 8 – Empathy and the Post-Apocalyptic Imagination
- Due: Critical Reflection #6
- Dick, Do Androids Dream of Electric Sheep?
Week 9 – Rick & Sisyphus
- Due: Critical Reflection #7
- Dick, Do Androids Dream of Electric Sheep?
Week 10 – Violence and Belonging
- Due: Critical Reflection #8
- Valente, The Past Is Red
Week 11 – Grief and Power
- Due: Proposal
- Valente, The Past Is Red
Week 12 – Tackling the Future
- Due: Final Project
- Valente, The Past Is Red
First Year Creative Writing Course

Course Description
In this section of the course, students will explore creative writing in a variety of forms and genres through a combination of lectures, workshops, writing exercises, and assignments. By the end of the course students will have gained a broader understanding of creative writing and its generic conventions as well as have some idea of how to incorporate the specific, practical techniques of writing and storytelling into their own craft. Each week we’ll look at an element of creative writing that traverses poetry, fiction, and creative nonfiction.
Required Texts
- Essays and literary texts for each week are listed below. They are available either through the library, through open-access, or will be posted online.
Assignments in the Course
To demonstrate your engagement in the course, knowledge of the material, and proficiency in the skills taught during the term, you will complete various assignments building toward your final creative project. Each assignment type is described below. Please pay close attention to due dates.
Grade Distribution
Craft Analysis 20%
Writing Exercises 20%
Midterm Portfolio 15%
Final Portfolio 30%
Attendance & Workshop Participation 15%
Craft Analysis 20%
Students will complete a series of short creative nonfiction pieces (~800 words) that closely analyze a topic on craft covered throughout the semester.
Writing Exercises 20%
These will include theme- or perspective-specific practice on an element of creative writing covered throughout the semester.
Midterm Portfolio 15%
The midterm portfolio will include pieces of writing that the student has polished after workshopping the piece in the first half of the semester (up to 10 pages).
Final Portfolio 30%
The final portfolio will consist of pieces of writing that the student has compiled during the semester (up to 20 pages). The student will preface their portfolio with a ~3 page reflection on their learning, writing process, and portfolio theme.
Attendance & Workshop Participation 15%
Writing and revision are at the heart of creative writing as a discipline, from introductory courses to the very highest levels of craft study. It is only through communal effort, engagement with the material, and a willingness to be vulnerable that students will be able to question, challenge, and develop their own understanding of creative writing.
Course Schedule
Week 1 – Getting to Know the Course
- Course Syllabus and welcome materials
- Lamott, “Shitty First Drafts”
Week 2 – What Even Is a “Story”? Narrative Basics
- Homework: Craft Analysis #1 – Writer’s Statement of Purpose
- Orwell, excerpts from Why I Write
Week 3 – Poetics
- Homework: Writing Exercise #1 – What Makes a Poem a Poem
- Davidson and Fraser, excerpts from Writing Poetry: Creative and Critical Approaches
- Adair, “Miscarriage”
- Keene, “Folks Are Right, My Nose Was Wide Open”
- Eliot, “The Love Song of J. Alfred Prufrock”
Week 4 – One Thing After Another (aka. Plot)
- Homework: Craft Analysis #2 – Why Do We Need Plot? Or Do We?
- Alison, excerpts from Meander, Spiral, Explode: Design and Pattern in Narrative
Week 5 – World Building
- Homework: Writing Exercise #2 – Build a World in 500 Words
- Clark, excerpts from Writing Tools: 55 Essential Strategies for Every Writer
- Hopkinson, “Inselberg”
Week 6 – Setting
- Homework: Craft Analysis #3 – When Setting Matters
- Clark, excerpts from Writing Tools: 55 Essential Strategies for Every Writer
- Lessing, “A Man and Two Women”
Week 7 – Character & Characterization
- Due: Midterm Portfolio
- Goldberg, excerpts from Writing Down the Bones: Freeing the Writer Within
- Carroll, “The Walrus and the Carpenter”
Week 8 – Point of View
- Homework: Writing Exercise #3 – Pointing Out the Point of View
- Le Guin, excerpts from Steering the Craft: A 21st-Century Guide to Sailing the Sea of Story
- Compton, “1,360 FT3 (38.5 M3)” from The Outer Harbour
Week 9 – Voice, Tone, & Style
- Homework: Writing Exercise #4 – Shifting Voice, Manipulating Style
- Bradbury, excerpts from Zen in the Art of Writing
- Washuta and Warburton (editors), excerpts from The Shapes of Native Nonfiction
- Lyscott, “3 Ways to Speak English”
Week 10 – Playing with the Universe
- Homework: Writing Exercise #5 – Writing about a Significant Object
- Atwood, excerpts from Negotiating with the Dead
- Miller, excerpts from On Not Being Someone Else: Tales of Our Unled Lives
Week 11 – Reimagining the Writing Life
- Homework: Craft Analysis #4 – Why Revise?
- Browne and King, excerpts from Self-Editing for Fiction Writers
- Dillard, excerpts from The Writing Life
Week 12 – Finally, The End
- Final Portfolio Due
Second Year Creative Writing Course

“When you write what you know, you stay in control. One of the first things I encourage my writing students to do is lose control – say what they want to say, break structure.”
― Natalie Goldberg
Course Description
Before we can break the rules, we need to make sure we understand them and how they work. Building on foundational creative writing techniques, this course focuses on process rather than product. We’ll start by considering how writing works as a “gift” and why we write and what it means to write, while also thinking about the importance of influence in our own craft. Over the course of the semester, we’ll talk about and engage in the steps necessary in developing a writing practice by encountering poetry, short stories, fiction, creative nonfiction, and drama. We will consider literary and creative writing theory from writers spanning a wide range of backgrounds and perspectives and explore their contents and contexts through writing of our own. Finally, we’ll examine the role of writing and art in today’s contemporary context, including how this context is shaped in a variety of ways by individuals, institutions, and grassroots organizations, before considering how we might go about publishing work or otherwise becoming involved with a writing community.
Students should be cautioned that the works on this course syllabus confront sexual violence, misogyny, racism, settler colonialism, national and class prejudice, and other troubling—and very real—issues.
Required Texts
- Dionne Brand, Salvage: Readings from the Wreck
- Caryl Churchill, Love and Information
- Junie Désil, eat salt | gaze at the ocean
- Mina Loy, The Lost Luna Baedeker
- Zadie Smith, NW
- Jane Urquhart (editor), Penguin Book of Canadian Short Stories
Essays and literary texts for each week are listed below. Excerpts from larger works are available either through the library, through open-access, or will be posted online.
Assignments in the Course
To demonstrate your engagement in the course, knowledge of the material, and proficiency in the skills taught during the term, you will complete various assignments building toward your final creative project. Each assignment type is described below. Please pay close attention to due dates.
Grade Distribution
Weekly Writing Homework 30%
Midterm Portfolio 20%
Final Portfolio 30%
Attendance & Workshop Participation 20%
Weekly Writing Homework 30%
There are ten (10) short “homework” writing tasks. Each responds to an aspect of writing as a craft and practice. These are meant to help you develop writing that you might include in your portfolios—they can influence your portfolio or can be workshopped and revised for your midterm and final portfolios.
Midterm Portfolio 20 %
The midterm portfolio will include pieces of writing that the student has polished after workshopping their writing in the first half of the semester. The portfolio will be a combination of poetry and a short story or stories that have been workshopped and revised (10 to 12 pages inclusive).
Final Portfolio 30%
The final portfolio will consist of a variety of creative writing that the student has complied during the semester. The portfolio will need to include samples from the fiction, drama, and creative nonfiction modules; however, these could be revised works from earlier in the semester that have incorporated aspects of the fiction, drama, and creative nonfiction elements we discussed later in the semester. If students would like to submit a revised version of an earlier piece from their portfolio, they need to consult with the instructor. The portfolio must also include the revised artist’s manifesto as a reflection on the student’s work during the semester and the themes they explore in their final portfolio.
Attendance & Workshop Participation 20%
Writing and revision are at the heart of creative writing as a discipline, from introductory courses to the very highest levels of craft study. It is only through communal effort, engagement with the material, and a willingness to be vulnerable that students will be able to question, challenge, and develop their own understanding of creative writing.
Course Schedule
Week 1 – Getting to Know the Course
- Course Syllabus and welcome materials
Week 2 – Review of Craft
- Homework #1: artist’s manifesto
- Hyde, excerpts from The Gift
- Lethem, “The Ecstasy of Influence”
Week 3 – Poetry Module
- Homework #2: everyday poetics
- Loy, The Lost Luna Baedeker
Week 4 – Poetry Module
- Homework #3: responding with poetry
- Désil, eat salt | gaze at the ocean
Week 5 – Short Story
- Homework #4: eavesdropping
- MacLeod, Vassanji, Thien, Mistry, Winter, & Huggan from Penguin Book of Canadian Short Stories
Week 6 – Short Story
- Due: Midterm Portfolio
- Crummey, Lee, Ondaatje “Aunts,” Birdsell, Findley, Atwood, & Ross from Penguin Book of Canadian Short Stories
Week 7 – Fiction
- Homework #5: reflections on the craft of extended prose fiction
- Smith, NW
Week 8 – Fiction
- Homework #6: practicing humour
- Smith, NW
Week 9 – Fiction
- Homework #7: the art of delay
- Smith, NW
Week 10 – Drama
- Homework #8: writing dialogue
- Churchill, Love and Information
Week 11 – Drama
- Homework #9: revising your artist’s manifesto
- Churchill, Love and Information
Week 12 – Creative Nonfiction
- Homework #10: critical reflections
- Brand, Salvage: Readings from the Wreck
Week 13 – Review
- Due: Final Portfolio
Post Colonial Fiction (2nd year course)

Cildo Meireles, Insertions into Ideological Circuits 2: Banknote Project, 1970. https://www.tate.org.uk/art/artworks/meireles-insertions-into-ideological-circuits-2-banknote-project-t12528
Course Description
In 1970, Cildo Meireles started the Banknote Project during the military dictatorship in Brazil. The caption from the artwork above notes that the project operates when the currencies are returned to circulation, demonstrating both how ideology circulates as a form of currency and how something as seemingly benign as currency can be repurposed to create political awareness. In this section of the course, we’ll be looking at how colonialism, with ties to such ideological systems as capitalism, creates ideological wounds as a form of currency that creates political awareness. Colonial wounds can take the form of cultural eradication and genocide or seemingly innocuous forms of disremembering. In the wake of these colonialist histories and violences, authors demonstrate survivance or what Anishinaabe scholar Gerald Vizenor describes as active resistance and continuation in the face of colonization and assimilation. Each of the novels, from very different geographical locations, touch of the wide-ranging effects of colonization. They also challenge readers to think outside what can be considered the traditional white lens of literary approaches to reading. Encountering difficulty in these texts will allow students to expand their understanding of what it means to survive and persist despite colonialist wounds.
Students should be cautioned that the works on this course syllabus confront sexual violence, misogyny, racism, settler colonialism, national and class prejudice, and other troubling—and very real—issues; students should be prepared to be challenged and disturbed by what they read and witness as part of the learning process.
Required Texts
- Lamming, In the Castle of My Skin (1953)
- Guma, A Walk in the Night (1962)
- Roy, The God of Small Things (1997)
- Pamuk, My Name Is Red (1998)
- Desai, The Inheritance of Loss (2006)
- Wright, Carpentaria (2006)
- Additional essays and texts for each week are listed below. They are available either through the library, through open-access, or will be posted online.
Assignments in the Course
To demonstrate students’ engagement in the course, knowledge of the material, and proficiency in the skills taught during the term, students will complete various assignments building toward a final project. Each assignment type is described below. Please pay close attention to due dates.
Grade Distribution
Critical Reflections 30%
Midterm Essay 20%
Proposal 10%
Final Project 25%
Attendance & Class Participation 15%
Critical Reflections – 30%
These reflections can be about personal experience, questions, concerns, or how the week’s readings capture an aspect of colonialist wounds and/or postcolonial survivance. However, the writing must provide at least one citation (quote, summary, or paraphrase) to anchor the ideas. Answers should be specific and detailed, even if they are not fully formed thoughts. Each reflection should be no more than one (1) page, double spaced.
Midterm Essay 20%
The midterm essay will be a focused, 1000-word essay on the topic of colonialist wounds and/or postcolonial survivance and one (1) reading students have done so far in the course. No additional research is required.
Proposal 10%
This assignment will give students a chance to think about what they would like to do for their final project. The final project may be an essay, artwork, archive, a photo journal, scrapbook, illustration, podcast, vlog, op-ed, creative non-fiction essay, or any other type of project that focuses on some aspect of colonialist wounds and/or postcolonial survivance discussed in the course. Creative projects must be accompanied by a critical introduction. Students are encouraged to discuss their ideas with the instructor before submitting the proposal. The proposal should demonstrate how the project will critically engage with the course’s materials and theme of colonialist wounds and/or postcolonial survivance.
Final Project 25%
This project gives students a chance to respond to the course’s content in a variety of ways. Essays should be 8-10 pages in length with a works cited. Creative projects should be accompanied by a 2-3 page critical introduction that cites material from the course and includes a reflection on what colonialist wounds and/or postcolonial survivance means to the student and as a boarder topic explored in the course.
Attendance & Class Participation 15%
Participation marks depend on the student’s attendance but also their engagement in class. On the first day, we will collaboratively draw up an agreement for what “counts” as participation. This might include contributing to class discussion and group work, or other forms of participation that adapt to students’ learning needs and abilities.
Course Schedule
Week 1: Getting to Know the Course
- Young, “Colonialism and the Politics of Postcolonial Critique”
- Lamming, In the Castle of My Skin
- Critical Reflection #1: What does postcolonialism look like in the everyday?
Week 2
- Kortenaar, “George Lamming’s In the Castle of My Skin: Finding Promise in the Land”
- Lamming, In the Castle of My Skin
- Critical Reflection #2
Week 3
- Wolfe, “History and Imperialism: A Century of Theory, from Marx to Postcolonialism”
- Guma, A Walk in the Night
- Critical Reflection #3
Week 4
- Wade, “Art and Morality in Alexa La Guma’s A Walk in the Night”
- Guma, A Walk in the Night
- Critical Reflection #4
Week 5
- Spivak, “Can the Subaltern Speak?”
- Roy, The God of Small Things
- Critical Reflection #5
Week 6
- Bose, “In Desire and in Death: Eroticism as Politics in Arundhati Roy’s The God of Small Things”
- Roy, The God of Small Things
- Due: Midterm Essay
Week 7
- Tlostanova, “How to Disengage from the Coloniality of Perception”
- Pamuk, My Name Is Red
- Critical Reflection #6
Week 8
- Wasif, “Of Masters and Subalterns: Shifting Narratives in Orhan Pamuk’s My Name Is Red”
- Pamuk, My Name Is Red
- Critical Reflection #7
Week 9
- Vizenor, “Aesthetics of Survivance”
- Desai, The Inheritance of Loss
- Due: Proposal
Week 10
- Jackson, “Globalization, Diaspora, and Cosmopolitanism in Kiran Desai’s The Inheritance of Loss”
- Desai, The Inheritance of Loss
- Critical Reflection #8
Week 11
- Butler, “After Loss, What Then?” from Loss: The Politics of Mourning
- Wright, Carpentaria
- Critical Reflection #9
Week 12
- Ng, “Translocal Temporalities in Alexis Wright’s Carpentaria”
- Wright, Carpentaria
- Critical Reflection #10
Week 13: Final Week of Classes
- Wright, Carpentaria
- Due: Final Project
Global Fantasy Literature (3rd year course)

James Jean, Masquerade, 2016.
Course Description
In this section of the course, we’ll be looking at subaltern and postcolonial fantasy literature from around the globe. At times, the fantasy might take on a dystopian lens or use magic realism. In each instance, fantasy speaks to the ability to imagine otherwise. The course is situated in writing back against power as a political act. Each novel will coincide with a particular way of thinking about writing back to and against regimes of power, most notably in the form of colonization, racism, and sexism. Fantasy itself becomes a technique of worldbuilding otherwise, imagining dreamscapes of possibility in the dystopian past and present of the real world. But discourse on the “real” will also be part of the course. What makes something “real” or “fantasy”? How do we come to define “fantasy”? How does it link to our understanding of imagination and memory? Over the course of the semester, we’ll explore these ideas through novels and short stories to consider our own abilities to enter into postcolonial dreamscapes and imagine otherwise.
Students should be cautioned that the works on this course syllabus confront sexual violence, misogyny, racism, settler colonialism, national and class prejudice, and other troubling—and very real—issues; students should be prepared to be challenged and disturbed by what they read and witness as part of the learning process.
Required Texts
- Rushdie, Midnight’s Children (1981)
- Murakami, A Wild Sheep Chase (1982)
- Hopkinson, Midnight Robber (2000)
- Robinson, Monkey Beach (2000)
- Lai, Salt Fish Girl (2002)
- Hopkinson and Mehan (eds), So Long Been Dreaming (2004)
- Additional essays and texts for each week are listed below. They are available either through the library, through open-access, or will be posted on online.
Assignments in the Course
To demonstrate students’ engagement in the course, knowledge of the material, and proficiency in the skills taught during the term, students will complete various assignments building toward a final essay in the form of a manifesto. Each assignment type is described below. Please pay close attention to due dates.
Grade Distribution
Critical Dialogues 15%
Autoethnographic Essay 20%
Critical Engagement Essay 20%
Final Essay: A Postcolonial Manifesto 30%
Attendance & Class Participation 15%
Critical Dialogues – 15%
Critical dialogues will be online and interactive. There will be several critical dialogues posted to which students should 1) first post a response and 2) then respond to a minimum of two (2) classmates, either by affirming something they’ve noticed, offering a question for them to further consider, or challenging them to think about their response from a different perspective. Each dialogue will be worth 3%. Full marks will be given for: 1) a thoughtful/thought-provoking post and 2) thoughtful/thought-provoking, respectful engagement with fellow students’ writing and thoughts.
These reflections can be about personal experience, questions, concerns, or how the student considers the prompt. The writing must provide at least one citation (quote, summary, or paraphrase) to anchor the ideas. Answers should be specific and detailed, even if they are not fully formed thoughts. Each reflection should be around 150-200 words.
Autoethnographic Essay – 20%
In a 3-4 page, double spaced essay, students should analyze their own experience to understand the cultural, political, and social meanings of postcolonial dreamscapes, fantasy, and imagining otherwise. While there is a creative element to this kind of essay, it should also critically engage with the materials we have covered in weeks 1-5 of the course. The essay is an opportunity to do a critical self-reflection in the context of issues and questions raised in class.
Students are encouraged to write their paper in the first person as part of an analysis of their own subject position in relation to course materials and topics. We will discuss autoethnography in Lorde’s writing and other readings in the course. The essay should incorporate a critical reflection on at least 1 novel and 2 assigned readings.
Critical Engagement Essay – 20%
This essay will ask students to critically engage with the postcolonial themes, fantasy, and imagining otherwise presented in weeks 6-9 of the course. In this essay, students will be required to think critically about the theory we have covered as it applies to the fictional works and how the texts reinforce certain ideas about fantasy and/or challenge and re-invent what it means in the wake of colonization and imperialism.
This essay should be 3-4 pages, double-spaced, and engage closely (through proper citation) with at least one (1) novel and three (3) of the assigned readings covered in class in recent weeks.
Final Essay: A Postcolonial Manifesto – 30%
Each text in the course has presented itself as a pseudo-manifesto on postcoloniality, fantasy, and imagining otherwise. For the final essay, students will be asked to creatively respond to the readings in the course in the form of a manifesto, focussing on Lai’s Salt Fish Girl and pieces from So Long Been Dreaming. Students may trace certain themes throughout the course but should focus on how those themes are especially apparent in the final texts we’ve read. In taking on the form of a manifesto, the essay should discuss the implications of imagining otherwise, thinking through the political connotations of what it means to create fantasy in the context of a postcolonial dreamscape. The assignment asks students to consider both the limitations and possibilities of a politics of imaging otherwise as we move towards a more just future. This means that, in part, the final assignment in the course asks students to do the work of theorizing contemporary postcolonialism(s).
What kind of postcolonialism(s) will we need for the future? What kind of fantasy do we need now? And, finally, how can dreamscapes, generally, speak to specific political contexts? The final essay will have a research component and should be 8-10 pages, double spaced.
Attendance & Class Participation 15%
Participation marks depend on the student’s attendance but also their engagement in class. On the first day, we will collaboratively draw up an agreement for what “counts” as participation. This might include contributing to class discussion and group work, or other forms of participation that adapt to students’ learning needs and abilities.
Course Schedule
Week 1: Getting to Know the Course
- Mobley, “Toward a Definition of Fantasy Fiction”
- Rushdie, Midnight’s Children
- Critical Dialogue #1: What is Fantasy?
Week 2
- Zamora and Faris, “Introduction: Daiquiri Birds and Flaubertian Parrot(ie)s”
- Rushdie, Midnight’s Children
Week 3
- Riemenschneider, “Global Fantasy – Glocal Imagination”
- Mohanty, “Under Western Eyes”
- Rushdie, Midnight’s Children
- Critical Dialogue #2: Magic Realism vs. Fantasy
Week 4
- Slocombe, “Haruki Murakami and the Ethics of Translation”
- Murakami, A Wild Sheep Chase
Week 5
- Lorde, “The Master’s Tools Will Never Dismantle the Master’s House”
- Lorde, “The Transformation of Silence into Language and Action”
- Murakami, A Wild Sheep Chase
- Due: Autoethnographic Essay
Week 6
- Martín-Albo, “The Frontier Myth and Racial Politics”
- Hopkinson, Midnight Robber
Week 7
- Mills, “Gender and Colonial Space” from Feminist Postcolonial Theory
- Hooks, “The Oppositional Gaze: Black Female Spectators”
- Hopkinson, Midnight Robber
- Critical Dialogue #3: Travelling Worlds
Week 8
- Ouyang, “Magical Realism and Beyond: Ideology of Fantasy”
- Robinson, Monkey Beach
Week 9
- Banerjee, “Dystopia and the Postcolonial Nation”
- Robinson, Monkey Beach
- Due: Critical Engagement Essay
Week 10
- Cornum and Moynagh, “Decolonial (Re)Visions of Science Fiction, Fantasy and Horror”
- Lai, “Familiarizing Grist Village: Why I Write Speculative Fiction”
- Lai, Salt Fish Girl (2002)
Week 11
- Cardozo and Subramaniam, “Truth Is Stranger: The Postnational ‘Aliens’ of Biofiction”
- Lai, Salt Fish Girl
- Critical Dialogue #4: Imagining Otherwise
Week 12
- Barr, “Fantastic Language/Political Reporting: The Postcolonial Science Fiction Illocutionary Force Is with Us”
- Hopkinson, “Speaking in Tongues: An Interview with Science Fiction Writer Nalo Hopkinson”
- Hopkinson and Mehan (eds), So Long Been Dreaming (2004)
- Critical Dialogue #5: Building Storyworlds
Week 13
- Bould, “The Ships Landed Long Ago: Afrofuturism and Black SF”
- Young, “Introduction” from Race and Popular Fantasy Literature
- Hopkinson and Mehan (eds), So Long Been Dreaming (2004)
- Due: Final Essay
Queer Theories: Gender, Sexuality, and Ideology (3rd year course)

Installation view of The Archival Impulse: 40 Years at LACE (2018-2020), curated by Matias Viegener. Photo by Chris Wormald. https://welcometolace.org/lace/2020-current-year/the-living-queer-archive-at-lace/
Course Description
The “queer” has come to be thought of as a process rather than an identity. The queering process marks an instance of rupture, while at the same time it calls for attention to the histories that precede the announcement of its arrival. But, if the queer is understood as a disturbance, what does it disturb? What is ruptured when the queer arrives as a mark in history? What dominant narratives surrounding gender and sexuality are interrupted with the idea of the queer as deviance? How does the queer resituate what we know and think about cultural spaces? Queer theory gives us tools to answer these questions as we think about the practice of meaning making in the terrain of gender and sexuality. We will treat the novels, theory, artwork, films, and digital exhibits as archival spaces to consider how they queer the terrain in specific cultural contexts.
This course has three goals. First, it is to survey the scholarly conversations surrounding queer theory since its emergence. Second, it is to teach queer theory as it has emerged in contemporary practice, thinking about how it differs from and expands feminist theory, and what we can do with it in local, national, and transnational contexts. Third, it is to teach the skills required to use theory as a rhetorical lens to address contemporary concerns, from our own experiences to the way geopolitics and histories have created space for non-normative genders and sexualities and how that discourse plays out.
Required Texts/Media
- Sharman, The Rocky Horror Picture Show (1975)
- Kureishi, The Buddha of Suburbia (1990)
- Duiker, The Quiet Violence of Dreams (2001)
- Glass, Love Lies Bleeding (2024)
- Osunde, Necessary Fiction (2025)
- Additional essays, texts, and exhibits for each week are listed below. They are available either through the library, through open-access, or will be posted on online.
Assignments in the Course
To demonstrate students’ engagement in the course, knowledge of the material, and proficiency in the skills taught during the term, students will complete various assignments building toward the final creative project. Each assignment type is described below. Please pay close attention to due dates.
Grade Distribution
Learning Journals 20%
Introspection Essay 20%
Proposal for Final Project 5%
Presentation of Preliminary Findings 10%
Final Creative Project 30%
Attendance & Class Participation 15%
Learning Journals – 20%
For every class meeting, students will prepare a brief, one (1) page, double spaced, written response to the week’s subject-specific readings. These journals can be about the student’s personal experience, questions they might have, concerns, or how the week’s topic interacts with other ideas and themes we’ve encountered. Each entry must provide at least one citation (quote, summary, or paraphrase) from the reading. The student’s answers should be specific and detailed, even if they are not fully formed thoughts.
These brief entries serve a number of important purposes. First, they offer students an opportunity to document their learning. Second, the journals help to facilitate class discussions by providing material for students to reference. Third, they allow students to track important ideas in the readings that they might use in their final creative project. And, finally, they allow the instructor to formatively assess the student’s comprehension of materials throughout the term in order to address learning needs in the classroom.
Introspection Essay – 20%
In lieu of a midterm exam, students will submit an introspective analysis of their own gendered relationship to the queer theory we have covered in the first half of the semester. This essay is an opportunity for students to demonstrate their understanding of the historical and rhetorical content as well as their capacity to situate themselves in relation to it.
The essay should be 4-5 pages, double-spaced, and engage closely (through proper citation) with at least four (4) of the assigned readings covered in class. While the essay may be structured as a narrative, it should also include elements of analysis, synthesis, and argumentation that make a case for how queer theory affects the student directly or indirectly.
Proposal for the Final Project – 5%
The latter half of the semester will include readings that help students think about the queer and archival practices while they prepare for their final creative projects.
Students will propose an object (literary, cinematic, artistic, etc.), on which to focus, that queers the terrain of a cultural space for their presentation and final project. The proposal should be one (1) page, double spaced, and give an overview of the project, the student’s research plan, and the shape the final creative project will take. The purpose of the proposal is to have students plan their final projects in advance. This also allows me to offer feedback and direction on the project.
Presentation of Preliminary Findings – 10%
As the semester ends, this presentation gives students the chance to share what they’ve learned. The presentations will take place in the final weeks of the course and should be about 10 minutes in length. There should be a visual component to the student’s presentation.
Final Creative Project – 30%
The final assessment for this semester will help students apply what they’ve learned in class and how it applies to an example that queers the terrain of a cultural space. The “example” might be an event in the news, a protest, an exhibit, or a show, a novel, a film, works of art, or some kind of “found” cultural object that demonstrates a “queering.”
Using their experience from the course, students will submit a final creative project, such as an archive with a theoretical introduction, a digitally curated exhibition, a podcast, or a vlog. Students can also choose to submit a final essay (8-10 pages in length) in lieu of a creative project. Students will receive confirmation on the form of their final projects when they submit their proposal.
The type of project will be proposed early enough that the student will be able to do the necessary research and gathering of materials before the presentation of their preliminary findings and with enough time to turn those findings into their final project.
This project will need to include a nuanced understanding of some of the challenges inherent within queer theory, as well as how queer theory has investigated the deviant and “failure” as a way of reclaiming or taking up new cultural spaces. The project will be graded on the following:
- Rhetorical engagement with queer theory
- Synthesis of materials covered in class, applied to the project’s “found object”
- Research of 2-3 articles about the object or topic of focus that connects it to the course’s theme of “queering the terrain”
- Clear and professional presentation of ideas
Attendance & Class Participation – 15%
Participation marks depend on the student’s attendance but also their engagement in class. On the first day, we will collaboratively draw up an agreement for what “counts” as participation. This might include contributing to class discussion and group work, or other forms of participation that adapt to students’ learning needs and abilities.
Course Schedule
Week 1: Getting to Know the Course
- Course Syllabus and welcome materials
- Foucault, excerpts from The History of Sexuality
Week 2: What is Queer Theory?
- Sedgwick, “Introduction: Axiomatic”
- Berlant and Warner, “What Does Queer Theory Teach Us about X?”
- Kureishi, The Buddha of Suburbia
- Learning Journal #1
Week 3: Orientations
- Butler, “Critically Queer”
- Ahmed, “Orientations: Toward a Queer Phenomenology”
- Kureishi, The Buddha of Suburbia
- Learning Journal #2
Week 4: Queering the Process
- Edelman, “The Future Is Kid Stuff”
- Warner, “The Ethics of Sexual Shame” & “What’s Wrong with Normal?”
- “Pride on the Prairies: Queer History in Saskatchewan (1969-2020)” digital exhibit hosted by the Diefenbaker Canada Centre
- Learning Journal #3
Week 5: Queer/in(g) the Archives
- Brim and Ghaziani, “Introduction: Queer Methods.”
- Clark, “Finding the Subject: Queering the Archive”
- Ahmed, “Unhappy Queers”
- Digital archives of Queer Art shows in Regina
- https://www.artgalleryofregina.ca/thedragexplosion
- https://dunloplearning.ca/exhibitions/off-centre
- Due: Introspection Essay
Week 6: Politics and Histories
- Love, “Introduction” & “Epilogue: The Politics of Refusal”
- Sharman, The Rocky Horror Picture Show (in-class screening, time permitting)
- Learning Journal #4
Week 7: The Queer Art of Failure
- Halberstam, “The Queer Art of Failure”
- Muñoz, “Introduction: Feeling Utopia” & “Stages: Queers, Punks, and the Utopian Performative”
- Glass, Love Lies Bleeding (in-class screening, time permitting)
- Learning Journal #5
Week 8: Transnational Queerness
- Bayramogly, Szulc, & Gajjala, “Transnational Queer Cultures and Digital Media: An Introduction”
- Liu, “Queer Transnationalisms”
- Duiker, The Quiet Violence of Dreams
- Learning Journal #6
- Due: Proposal for Final Project
Week 9: Postcolonial Queer
- Goldie, “Queerly Postcolonial”
- Spurlin, “Broadening Postcolonial Studies/Decolonizing Queer Studies”
- Rao, “Queer Questions”
- Duiker, The Quiet Violence of Dreams
- Learning Journal #7
Week 10: What in the Heterosexual?
- Jones, “Queer Heterotopias: Homonormativity and the Future of Queerness”
- Carroll, “Introduction” from Rereading Heterosexuality: Feminism, Queer Theory and Contemporary Fiction
- Osunde, Necessary Fiction
- Learning Journal #8
Week 11: Queering Research
- Amin, “Genealogies of Queer Theory”
- Chávez, “Introduction” & “Coming Out as Coalitional Gesture?”
- Osunde, Necessary Fiction
- Learning Journal #9
Week 12: Queerly Reparative
- Sedgwick, “Paranoid Reading and Reparative Reading; or, You’re So Paranoid, You Probably Think This Introduction Is About You” from Novel Gazing: Queer Readings in Fiction
- Learning Journal #10
- Presentations of Preliminary Findings
Week 13: Final Week of Class
- Presentations of Preliminary Findings
- Due: Final Creative Project
Another World Is Possible: Alternative Realities (4th year / honours undergraduate course)

Herman Potgieter, The Good, the Bad, and the Pretty Ugly, 2016.
Course Description
This section of the course explores “alternative realities” through the so-called ugly. In their introduction to On the Politics of Ugliness, Ela Przybylo and Sara Rodrigues write that “ugliness seems to emerge as a property or attributes of places and bodies rather than a process that relies on an unjust distribution of value and power in relation to the workings of gender, ability, race, class, beauty norms, body size, health, sexuality, and age.” Given that ugliness can become a politics of resistance, we’ll explore the ugly over the course of the semester through postcolonial and diasporic global representations of racism, sexism, and othering. Each novel represents an “alternative realty” experienced through the ugly that functions as a social category that demarcates one’s rights and access to social, cultural, and political spaces. Given this, how can the ugly become a political discourse for better futures and other worlds? How do systems of seeing and being seen play into the discrimination built into the ugly? Is the ugly a site of social death or a space outside dominant narratives that allow bodies to exist in alternative realities full of possibility, potential, and resistance? Throughout the semester we’ll explore these questions while conceptualizing the ugly as an alternative reality.
Students should be cautioned that the works on this course syllabus confront sexual violence, misogyny, racism, settler colonialism, national and class prejudice, and other troubling—and very real—issues; students should be prepared to be challenged and disturbed by what they read and witness as part of the learning process.
Required Texts
- Kincaid, A Small Place (2000)
- Smith, On Beauty (2005)
- Ishiguro, Never Let Me Go (2010)
- Yang, Small Beauty (2016)
- Zumas, Red Clocks (2018)
- Vuong, On Earth We’re Briefly Gorgeous (2021)
- Additional essays and texts for each week are listed below. They are available either through the library, through open-access, or will be posted on online.
Assignments in the Course
To demonstrate students’ engagement in the course, knowledge of the material, and proficiency in the skills taught during the term, students will complete various assignments building toward their final essay. Each assignment type is described below. Please pay close attention to due dates.
Grade Distribution
Literature Review 15%
Book Review 10%
Midterm Essay 20%
Draft of Final Essay & Peer-Review 10%
Final Essay 30%
Attendance & Class Participation 15%
Literature Review – 15%
Students will sign up to review one of the assigned readings. They will present their review at the beginning of the class. The review should summarize the reading, offer a bit of context, and pull-out key concepts for discussion. At the end of their presentation, they should pose a general question to the class derived from the reading.
Book Review – 10%
Reviews are an important element of academic publishing. Often, they are one of the first publications a student will have. Students will sign up to review one of the novels in the course. Reviews give readers a general summary of a text and an informed opinion about the text’s value in a specific context. Reviews are not inherently positive or negative; they can describe what was more and less successful given a certain reader’s possible interest in a text. The review should be no more than 500 words and will be due depending on which text the student chooses.
Midterm Essay – 20%
This take-home essay will compare two (2) of the texts covered so far in class through the lens of “the ugly.” How does “the ugly” create an alternative reality in the texts? What kind of “ugly” does the text deal with? How do the texts refashion reality through “the ugly”? This essay will be 3-4 pages in length and does not require any additional research. The focus of the essay should be the comparison of the texts and readings covered in class that takes up the “ugly” as a politics of resistance.
Draft of Final Essay & Peer-Review – 10%
Students will submit a nearly complete draft of their final essay for peer-review. Peer-review is an essential element in academic writing beyond the classroom. It functions as a way for peers to offer informed and informative feedback on written work to improve the theory, organization, and/or premise of an essay. Expectations for the peer-review and guidelines will give the students a sense of direction for completing the review. The “reader’s report” will be ~500 words.
Final Essay – 30%
The final essay will be 10-12 pages and will have a research component. Students are welcome to theorize their own concept of “the ugly” in the paper. The essay should focus on 2-3 novels covered in the second half of the semester and include 3-4 secondary sources that are not part of the course materials.
Attendance & Class Participation 15%
Participation marks depend on the student’s attendance but also their engagement in class. On the first day, we will collaboratively draw up an agreement for what “counts” as participation. This might include contributing to class discussion and group work, or other forms of participation that adapt to students’ learning needs and abilities.
Course Schedule
Week 1: Getting to Know the Course
- Course Syllabus and welcome materials
- Novel: A Small Place
- Theory:
- Foley, “Fact, Fiction, and ‘Reality’”
- Mingus, “Moving Toward the Ugly: A Politic Beyond Desirability”
Week 2: Exploring the Unnatural
- Novel: A Small Place
- Theory:
- Peel, “Unnatural Feminist Narratology”
- Peel, “Who Sees and Who Speaks with Our Head? Non-normative Bodies, Minds, and Acts of Narration”
Week 3: The Politics of Ugliness
- Novel: On Beauty
- Theory:
- Ngai, excerpts from “Introduction” to Ugly Feelings
- Przybylo and Rodrigues, “Introduction: On the Politics of Ugliness”
Week 4: On the Not-Not Ugly
- Novel: On Beauty
- Theory:
- Kant, excerpts from “Critique of Judgement”
- Athanassoglou-Kallmyer, “Ugliness”
Week 5: The Abject
- Novel: Never Let Me Go
- Theory:
- Kristeva, excerpts from On the Powers of Horror
- Margiotta, “‘Abjection hurts’: Race, Class, Gender, and the Demand for a Contemporary Reworking on the Kristevan Abject”
Week 6: Monstrous Cruelty
- Novel: Never Let Me Go
- Theory:
- Steintrager, “Monstrous Appearances: Hogarth’s ‘Four Stages of Cruelty’ and the Paradox of Inhumanity”
- Collins, “Three faces of Cruelty: Towards a Comparative Sociology of Violence”
- Mayes, “Naturalizing Cruelty”
- Due: Midterm Essay
Week 7: Grief & Violence
- Novel: Small Beauty
- Theory:
- Butler, “After Loss, What Then?” & “Violence, Mourning, Politics”
- McIvor, “Bringing Ourselves to Grief: Judith Butler and the Politics of Mourning”
Week 8: Trans* Experience & the Ugliness of Loss
- Novel: Small Beauty
- Theory:
- Norwood, “Grieving Gender: Trans-Identities, Transition, and Ambiguous Loss”
- Halberstam, “Gender and the Queer/Trans* Undercommons”
- Davis, “Queer Void: Autoethnographic Notes on Queer Melancholy and Transgender Shame”
Week 9: In-between the Lines of Ugliness
- Novel: Red Clocks
- Theory:
- Fahs, “Imagining Ugliness: Failed Femininities, Shame, and Disgust Written onto the ‘Other’ Body”
- Johnson, “Apostrophe, Animation, and Abortion”
- Mahoney, “Writing So to Speak: The Feminist Dystopia”
Week 10: Ugly Acts
- Novel: Red Clocks
- Theory:
- De Beauvoir, excerpts from The Second Sex
- Petchesky, “Fetal Images: The Power of Visual Culture in the Politics of Reproduction”
- Cahill, “Abortion and Disgust”
Week 11: Ugly Realities, Alternative Truths
- Novel: On Earth We’re Briefly Gorgeous
- Theory:
- Wight, “Post-Truth, Postmodernism and Alternative Facts”
- Poole, “Memory, History, and Claims of the Past”
- Eber and Neal, “Memory, Constructed Reality, and Artistic Truth”
- Due: Draft of Final Essay & Peer-Review
Week 12: Ugly(ing) Memories
- Novel: On Earth We’re Briefly Gorgeous
- Theory:
- Cho, “‘We Were Born from Beauty’: Dis/Inheriting Genealogies of Refugee and Queer Shame”
- Ha and Tompkins, “‘The Truth Is Memory Has Not Forgotten Us’: Memory, Identity, and Storytelling”
- Bell, “The Ugly Gaze”
Week 13: Final Week of Class
- Novel: On Earth We’re Briefly Gorgeous (wrap)
- Due: Final Essay
gender & sexuality
Women’s & Gender Studies (3rd year course)

Is it? I thought it was gender-neutral? Lindsey LaMont via Unsplash
https://medium.com/fearless-she-wrote/the-problem-with-feminism-today-463493755b96
Course Description
This course critically examines the various ways feminists have pursued and continue to effect social, political, economic, and cultural change. The aim of this discussion-based course is to engage key issues, questions, and debates in contemporary feminist theory from the 1960s to the present. We begin by exploring liberal, radical, and materialist feminist thinking alongside its socio-political and economic contexts. Rather than a comprehensive overview, we focus on understanding key debates and concerns that continue into the present. As we build towards contemporary feminist theories, we will take into consideration how postmodermism and feminist understandings of the body, sexuality, masculinity, race, ability, and worldview impact our experiences of equity, equality, diversity, and inclusion.
In part, we’ll look at how activism plays an important role in contemporary feminisms and consider the rhetorical approach of the manifesto.
Learning Objectives
By coming to class prepared, curious, open-minded, and prepared to contribute to our classroom community, you will, by the end of the semester, achieve the learning objectives:
- Understand the range of issues feminists address
- Identify and draw from examples of feminist-friendly strategies to imagine effective change
- Engage in an activist thinking, analyzing a problem well and developing appropriate, effective language to apply it to your own experiences
- Engage your classmates (and their knowledge and skills, of course) in discussion and preparing your feminist manifesto, and, in turn, contribute your feedback and skills to their projects
- Read more thoughtfully, speak more confidently, and write more comfortably, in a variety of formats
- Better envision yourself as an empowered, effective feminist/activist: one who knows their strengths and weaknesses, and can assess and use available resources to contribute to the building of a better, more just, more feminist world
Reading List
Books
- Adichie, Chimamanda Ngozi. We Should All Be Feminists. Vintage Books, 2015.
- Ahmed, Sara. The Feminist Killjoy Handbook: The Radical Potential of Getting in the Way. Basic Books, 2023.
- hooks, bell. Feminism Is for Everybody: Passionate Politics. Routledge, 2015.
- Kendall, Mikki. Hood Feminism: Notes from the Women that a Movement Forgot. Viking, 2020.
Articles/Chapters
- Banet-Weiser, Sarah. “Postfeminism and Popular Feminism.” Feminist Media Histories, 4.2, 2018, pp. 152-56.
- Bettcher, Talia Mae. Excerpts from Beyond Personhood: An Essay in Trans Philosophy. U of Minnesota P, 2025.
- Butler, Jess. “For White Girls Only?: Postfeminism and the Politics of Inclusion.” Feminist Formations, 25.1, 2013, pp. 35-58.
- Butler, Judith. “Subjects of Sex/Gender/Desire,” “Subversive Bodily Acts,” & “Conclusion: From Parody to Politics” from Gender Trouble: Feminism and the Subversion of Identity, 1990, Routledge, 2007, pp. 1-46, 107-93, 194-204.
- Davis, Angela, Erica Meiners, and Beth Richie. Excerpts from Abolition. Feminism. Now. Haymarket Books, 2022.
- Firestone, Shulasmith. Excerpts from The Dialectic of Sex: The Case for Feminist Revolution. 1970. Farrar, Straus and Giroux, 2003.
- Genz, Stéphanie. “Third Way/ve: The Politics of Postfeminism.” Feminist Theory, 7.3, 2006, pp. 333-53.
- Haraway, Donna. “The Cyborg Manifesto: Science, Technology, and Socialist-Feminism in the Late Twentieth Century” from Simians, Cyborgs, and Women: The Reinvention of Nature, Routledge, 1991, pp. 149-181.
- Hillstrom, Laurie Collier. “Overview of the #MeToo Movement” & “Landmark Events” from The #Me Too Movement, Bloomsbury Publishing, 2018, pp. 1-8, 9-68.
- Lorde, Audre. “The Master’s Tools Will Never Dismantle the Master’s House” & “Age, Race, Class, and Sex: Women Redefining Difference” from Sister Outsider, Crossing Press, 2007, pp. 110-13, 114-23.
- Loy, Mina. “Feminist Manifesto (1914)” from The Last Lunar Baedeker, Farrar, Straus and Giroux, 1997, p. 153-56.
- McRobbie, Angela. “Post-Feminism and Popular Culture.” Feminist Media Studies, 4.3, 2004, pp. 255-264.
- Millet, Kate. “Instances of Sexual Politics” & “Theory of Sexual Politics” from Sexual Politics. 1969. Columbia UP, 2016.
- Paglia, Camille. Excerpts from Free Women, Free Men: Sex, Gender, Feminism. Pantheon Books, 2017.
- Spivak, Gayatri Chakravorty. “Can the Subaltern Speak?” from Marxism and the Interpretation of Culture, U of Illinois P, 1988, pp. 267-310.
- Wunker, Erin. Excerpts from Notes from a Feminist Killjoy: Essays on Everyday Life. BookThug, 2016.
Assignments in the Course
To demonstrate your engagement in the course, knowledge of the material, and proficiency in the skills taught during the term, you will complete various assignments building toward your final creative project. Each assignment type is described below. Please pay close attention to due dates.
Grade Distribution
- Literature Review 10%
- Midterm Essay #1 20%
- Midterm Essay #2 25%
- Final Paper: A Feminist Manifesto 30%
- Attendance & Class Participation 15%
Literature Review – 10%
Students will sign up to review one of the assigned readings. They will present their review at the beginning of the class. The review should summarize the reading, offer a bit of context, and pull-out key concepts for discussion. At the end of their presentation, they should pose a general question to the class derived from the reading.
Midterm Essay #1 (Autoethnography Essay) – 20%
In a 3-4 page, double spaced essay, students should analyze their own experience to understand the cultural, political, and social meanings of feminism. While there is a creative element to this kind of essay, it should also critically engage with the materials we have covered in weeks 1-4 of the course. The essay is an opportunity to do a critical self-reflection in the context of issues and questions raised in class.
You are encouraged to write your paper in the first person as part of an analysis of your own subject position in relation to course materials and topics. We will discuss autoethnography in Lorde’s writing and other readings in the course. The essay should incorporate a critical reflection on at least 2 assigned readings. If you would prefer to submit creative prose or poetry, a musical selection, a podcast episode, or some other multimedia format, please be in touch with me.
Midterm Essay #2 (Critical Engagement Essay) – 25%
The second midterm essay will ask students to critically engage with the feminism presented in week 5-8 of the course. In this essay, students will be required to think critically about feminism, the metaphor of feminist “waves,” and discuss some of the concerns posed by third-wave feminism and postfeminism.
This essay should be 4-5 pages, double-spaced, and engage closely (through proper citation) with at least four (4) of the assigned readings covered in class in recent weeks.
Final Paper: A Feminist Manifesto– 30%
Since feminism situates itself in the physical experience, calling for individuals to take up certain kinds of spaces, the final essay will look at the materiality and phenomenology of feminism. What does the “post” in post-feminism signify? What is after feminism? Are we done with it? This essay will take on the form of a manifesto, imagining a feminism of the future and be a culmination of the student’s learning throughout the course. It asks students to consider both the limitations and possibilities of feminism moving forward. This means that, in part, the final assignment in the course asks students to do the work of theorizing contemporary feminism(s).
What kind of feminism(s) will we need for the future? What kind of feminism(s) do we need now? And, finally, how can feminism generally speak to political contexts specifically? This paper is an opportunity for you to choose your own “object” for analysis. It will have a research component and should be 8-10 pages, double spaced.
Attendance & Class Participation – 15%
Participation marks depend on the student’s attendance but also their engagement in class. On the first day, we will collaborative draw up an agreement for what “counts” as participation. This might include contributing to class discussion and group work, or other forms of participation that adapt to the students’ learning needs and abilities.
Course Schedule
Week 1 – Introductions to the Course
- Prepare for second class:
- Bring something to class that you consider “feminist.” It should be something—a meme, a song, a book, a pin, an item of clothing, etc—that you can show to the class and connect to “feminism” as you understand it.
- Readings
- Loy, “Feminist Manifesto”
- Delmar, “What Is Feminism?”
Week 2 – Some Historical Notes
- Readings
- Millet, “Instances of Sexual Politics” & “Theory of Sexual Politics”
- Firestone, excerpts from The Dialectic of Sex: The Case for Feminist Revolution
Week 3 – Diversifying Feminism
- Readings
- Lorde, “The Transformation of Silence into Language and Action”
- Mohanty, “Under Western Eyes”
- Connell, “The Social Organization of Masculinity”
Week 4 – The Master’s Tools
- Readings
- Lorde, “The Master’s Tools Will Never Dismantle the Master’s House” & “Age, Race, Class, and Sex: Women Redefining Difference”
- Spivak, “Can the Subaltern Speak?”
- Althusser, “Ideology and Ideological State Apparatuses”
- Midterm Essay #1 (Autoethnography Essay)
Week 5 – Gender Politics
- Readings
- Butler, “Subjects of Sex/Gender/Desire,” “Subversive Bodily Acts,” & “Conclusion: From Parody to Politics”
- Haraway, “The Cyborg Manifesto”
Week 6 – #MeToo and the Beginnings of Post-Feminism?
- Readings
- Hillstrom, “Overview of the #MeToo Movement” & “Landmark Events”
- McRobbie, “Post-Feminism and Popular Culture”
Week 7 – Postfeminism?
- Readings
- Genz, Stéphanie. “Third Way/ve: The Politics of Postfeminism”
- Butler, “For White Girls Only?: Postfeminism and the Politics of Inclusion”
- Banet-Weiser, “Postfeminism and Popular Feminism”
Week 8 – Hood Feminism
- Readings
- Adichie, We Should All Be Feminists
- Kendall, Hood Feminism: Notes from the Women that a Movement Forgot
- Midterm Essay #2 (Critical Engagement Essay)
Week 9 – Feminism Is for Every Body
- Readings
- hooks, Feminism Is for Everybody: Passionate Politics
Week 10 – Feminism and Its Killjoys
- Readings
- Wunker, excepts from Notes from a Feminist Killjoy: Essays on Everyday Life
- Bettcher, excerpts from Beyond Personhood
Week 11 – What Feminism Can Do for Men
- Readings
- Paglia, excerpts from Free Women, Free Men: Sex, Gender, Feminism
- Davis, Meiners, and Richie, excerpts from Abolition. Feminism. Now.
Week 12 – Taking Up Space
- Readings
- Ahmed, The Feminist Killjoy Handbook: The Radical Potential of Getting in the Way.
- Final Paper: A Feminist Manifesto
Women’s & Gender Studies (3rd year course)
*Note: This course was designed based on Saskatchewan as a location, but the archival and community-engagement structure of learning and assessments is adaptable to a wide variety of localities.

Installation view of The Archival Impulse: 40 Years at LACE (2018-2020), curated by Matias Viegener. Photo by Chris Wormald. https://welcometolace.org/lace/2020-current-year/the-living-queer-archive-at-lace/
Course Description
The “queer” has come to be thought of as a process, rather than an identity. The queering process marks an instance of rupture, while at the same time it calls for attention to the histories that precede the announcement of its arrival. But, if the queer is understood as a disturbance, what does it disturb? What is ruptured when the queer arrives as a mark in history? What dominant narratives surrounding gender and sexuality are interrupted with the idea of the queer as a deviance? How does the queer resituate what we know and think about cultural spaces? Queer theory gives us tools to answer these questions as we think about the practice of meaning making in the terrain of gender and sexuality.
Course Objectives
This course has three goals. First, it is to survey the scholarly conversations surrounding queer theory since its emergence in the 1990s. Second, it is to teach queer theory as it has emerged in contemporary practice, thinking about how it differs from and expands feminist theory, and what we can do with it in local, national, and transnational contexts. Third, it is to teach the skills required to use theory as a rhetorical lens to address contemporary concerns, from our own experiences to the way local histories have created space for non-normative genders and sexualities and how political discourse plays out.
In the first half of this course, we look at a wide range of queer theory to think about queer embodiment and performance. What is queer? How do bodies or projects become queer? If we think about queering as a process rather than an identity, where might we locate the queer?
In the second half of the course, we will look at the “Pride on the Prairies: Queer History in Saskatchewan (1969-2020)” digital exhibit hosted by the Diefenbaker Canada Centre and visit the Neil Richards Collection in the U of S archives to think about what kind of material constitutes the queer. These activities will culminate in a final project, where students create their own queer archive that expands out by considering the queer in a transnational context.
Reading List
- Ahmed, Sara. “Orientations: Toward a Queer Phenomenology.” GLQ, 12.4, 2006, pp. 543-74.
- —. “Unhappy Queers” from The Promise of Happiness, Duke UP, 2010, pp. 88-120.
- Amin, Kadja. “Genealogies of Queer Theory” from The Cambridge Companion to Queer Studies, edited by Siobhan Somerville, Cambridge UP, 2020, pp. 17-29.
- Bayramoglu, Yener, Łukasz Szulc, and Radhika Gajjala. “Transnational Queer Cultures and Digital Media: An Introduction.” Communication, Culture and Critique, 17, 2024, pp. 147-51.
- Berlant, Lauren. “Queer Nationality (written with Elizabeth Freeman)” from The Queen of America Goes to Washington City: Essays on Sex and Citizenship, Duke UP, 1997, pp. 145-173.
- Berlant, Lauren, and Michael Warner. “What Does Queer Theory Teach Us about X?” PMLA, 110.3, 1995, pp. 343-349.
- Brim, Matt, and Amin Ghaziani. “Introduction: Queer Methods.” Women’s Studies Quarterly, 44.3/4, 2016, pp. 14-27.
- Butler, Judith. “Critically Queer” from Playing with Fire: Queer Politics, Queer Theories, edited by Shane Phelan, Routledge, 1997, pp. 11-30.
- Vitry, Chloé. “Queering Space and Organizing with Sara Ahmed’s Queer Phenomenology.” Gender, Work, and Organization, 28.3, 2021, pp. 925-49.
- Chávez, Karma. “Introduction” & “Coming Out as Coalitional Gesture?” from Queer Migration Politics: Activist Rhetoric and Coalitional Possibilities, U of Illinois P, 2013, pp. 1-20, 79-112.
- Clark, Danielle. “Finding the Subject: Queering the Archive.” Feminist Theory, 5.1, 2004, pp. 79-83.
- Edelman, Lee. “The Future Is Kid Stuff” from No Future: Queer Theory and the Death Drive, Duke UP, 2004, pp. 1-31.
- Foucault, Michel. Excerpts from The History of Sexuality. Random House, 1978.
- Halberstam, Jack. “The Queer Art of Failure” from The Queer Art of Failure, Duke UP, 2011, pp. 87-121.
- Love, Heather. “Introduction” & “Epilogue: The Politics of Refusal” from Feeling Backward: Loss and the Politics of Queer History, Harvard UP, 2009, pp. 1-30, 146-63.
- Lui, Petrus. “Queer Transnationalisms” from Transnational American Literature, edited by Yogita Goyal, Cambridge UP, 2017, pp. 237-250.
- Muñoz, José Esteban. “Introduction: Feeling Utopia,” “Stages: Queers, Punks, and the Utopian Performative,” “After Jack: Queer Failure, Queer Virtuosity,” & “Conclusion: ‘Take Ecstasy with Me” from Cruising Utopia: The Then and There of Queer Futurity, New York UP, 2009, pp. 1-18, 97-114, 169-184, 185-190.
- Sedgwick, Eve Kosofsky. “Introduction: Axiomatic” from Epistemologies of the Closet, U of California P, 1990, pp. 1-63.
- Warner, Michael. “The Ethics of Sexual Shame” & “What’s Wrong with Normal?” from The Trouble with Normal: Sex, Politics, and the Ethics of Queer Life, Harvard UP, 1999, pp. 1-40, 41-80.
Assignments in the Course
To demonstrate your engagement in the course, knowledge of the material, and proficiency in the skills taught during the term, you will complete various assignments building toward your final creative project. Each assignment type is described below. Please pay close attention to due dates.
Grade Distribution
- Learning Journals 15%
- Introspection Essay 25%
- Proposal for Final Project 5%
- Presentation of Preliminary Findings 10%
- Final Creative Project 30%
- Attendance & Class Participation 15%
Learning Journals – 15%
For every class meeting, you will prepare a brief, one (1) page, double spaced, written response to the week’s subject-specific readings and the trip(s) to the archives. These journals can be about your personal experience, questions you might have, concerns, or how the week’s topic interacts with other ideas and themes we’ve encountered. Each entry must provide at least one citation (quote, summary, or paraphrase) from the reading. Your answers should be specific and detailed, even if they are not fully formed thoughts.
These brief entries serve a number of important purposes. First, they offer you an opportunity to document your learning. Second, they help to facilitate class discussions by providing material for you to reference. Third, they allow you to track important ideas in the readings that you might use in your final creative project. And, finally, they allow me to formatively assess your comprehension of the material throughout the term in order to address learning needs in the classroom.
Introspection Essay – 25%
In lieu of a midterm exam, students will submit an introspective analysis of their own gendered relationship to the queer theory we have covered in the first half of the semester. This essay is an opportunity for students to demonstrate their understanding of the historical and rhetorical content as well as their capacity to situate themselves in relation to it.
The essay should be 4-5 pages, double-spaced, and engage closely (through proper citation) with at least four (4) of the assigned readings covered in class. While the essay may be structured as a narrative, it should also include elements of analysis, synthesis, and argumentation that make a case for how queer theory affects the student directly or indirectly.
Proposal for the Final Project – 5%
The latter half of the semester will include readings that help us think about the queer in the archives while students prepare for their final creative projects.
Students will propose a focus on a specific archive, project, or event with a transnational aspect that queers the terrain of a cultural space for their presentation and final project. The proposal should be one (1) page, double spaced, and give an overview of the project, the student’s research plan, and the shape the final creative project will take.
The purpose of the proposal is to have students plan their final projects in advance. This also allows me to offer feedback and direction on the project.
Presentation of Preliminary Findings – 10%
As the semester comes to a close, this presentation gives students the chance to share what they’ve learned. The presentations will take place in the final weeks of the course and be 10 minutes in length. There should be a visual component to the student’s presentation.
Final Creative Project – 30%
The final assessment for this semester will help you apply what you’ve learned in class and how it applies to a transnational example that queers the terrain of a cultural space. The “example” might be an event in the news, a protest, an exhibit or a show, a novel, works of art, or some kind of “found” cultural object that demonstrates a “queering.”
Using their experience from the archives, students will submit a final creative project, such as an archive with a theoretical introduction or an analytical essay, a digitally curated exhibition, a podcast, or a vlog. Students will receive confirmation on the form of their final projects when they submit their proposal.
The type of project will be proposed early enough that the student will be able to do the necessary research and gathering of materials before the presentation of their preliminary findings and with enough time to turn those findings into their final project.
This project will need to include a nuanced understanding of some of the challenges inherent within queer theory, as well as how queer theory has investigated the deviant and “failure” as a way of reclaiming or taking up new cultural spaces. The project will be graded on the following:
- Rhetorical engagement with queer theory
- Synthesis of materials covered in class, applied to the project’s “found object”
- Research of 2-3 articles about the object or topic of focus that connects it to the course’s theme of “queering the terrain”
- Clear and professional presentation of ideas
Attendance & Class Participation – 15%
Participation marks depend on the student’s attendance but also their engagement in class. On the first day, we will collaborative draw up an agreement for what “counts” as participation. This might include contributing to class discussion and group work, or other forms of participation that adapt to the students’ learning needs and abilities.
Course Schedule
Week 1 – Introductions to the Course
- Readings
- Foucault, The History of Sexuality
Week 2 – What is Queer Theory?
- Readings
- Foucault cont’d
- Sedgwick, “Introduction: Axiomatic”
- Assignments Due: Learning Journal Entry 1
Week 3 – Queering the Terrain
- Readings
- Berlant and Warner, “What Does Queer Theory Teach Us about X?”
- Berlant, “Queer Nationality (written with Elizabeth Freeman)”
- Assignments Due: Learning Journal Entry 2
Week 4 – Orientations
- Readings
- Butler, “Critically Queer”
- Ahmed, “Orientations: Toward a Queer Phenomenology”
- Assignments Due: Learning Journal Entry 3
Week 5 – Queering the Process
- Readings
- Edelman, “The Future Is Kid Stuff”
- Warner, “The Ethics of Sexual Shame” & “What’s Wrong with Normal?”
- Assignments Due: Learning Journal Entry 3
Week 6 – Politics & History
- Readings
- Love, “Introduction” & “Epilogue: The Politics of Refusal”
- Muñoz, “Introduction: Feeling Utopia” & “Stages: Queers, Punks, and the Utopian Performative”
- Assignments Due: Introspection Essay
Week 7 – Queer/Failure
- Readings
- Halberstam, “The Queer Art of Failure”
- Muñoz, “After Jack: Queer Failure, Queer Virtuosity,” & “Conclusion: ‘Take Ecstasy with Me”
Week 8 – Queer Methodologies
- Readings
- Brim and Ghaziani, “Introduction: Queer Methods.”Clark, “Finding the Subject: Queering the Archive”
- Ahmed, “Unhappy Queers”
- Assignments Due: Proposal for Final Project & Learning Journal Entry 5
Week 9 – Queer History in Saskatchewan
- Media
- “Pride on the Prairies: Queer History in Saskatchewan (1969-2020)” digital exhibit
- “Rise Up!” digital archive of feminist activism
- Assignments Due: Learning Journal Entry 6
Week 10 – Transnational Queerness
- Readings
- Bayramogly, Szulc, & Gajjala, “Transnational Queer Cultures and Digital Media: An Introduction”Nealon, “White Meadows”
- Liu, “Queer Transnationalisms”
- Assignments Due: Learning Journal Entry 7
Week 11 – Research Methodologies
- Readings
- Amin, “Genealogies of Queer Theory”
- Chávez, “Introduction” & “Coming Out as Coalitional Gesture?”
Week 12 –Presentations
- Assignments Due: Presentations of Preliminary Findings & Final Creative Project
Feminist Philosophy / Cultural Studies / Women’s & Gender Studies (4th year / honours / graduate course)
Tissue from five weeks to nine weeks of pregnancy. Photograph: MYA Network
https://www.theguardian.com/world/2022/oct/18/pregnancy-weeks-abortion-tissue
Notes on Sensitive Content
This course covers a variety of sensitive content, including graphic images, medical issues, gender-based violence, sexual activity, hate speech or strong abusive language, discrimination, and stereotypes. Discussions of the content will require affective labour that can be taxing. Students may personally relate to the materials. I want you to feel safe in this class but need your help to do so. Please review the syllabus and assignments closely and discuss any concerns you may have with me privately as soon as possible (either over email or in office hours). You are responsible for navigating the materials of the class, and I am happy to give outlines or discuss specifics so that you may appropriately engage with materials that are likely to be emotionally challenging for you. Likewise, if you ever wish to discuss your personal reactions to course material with the class or with me afterwards, I welcome all discussions.
Course Description
Abortion has been around for centuries. Evidence of its practice as a form of birth control and reproductive health dates back to early Egypt; and abortion has been documented as a cultural practice in many Indigenous nations as well. What does this mean in the context of today? What language and imagery have we inherited that most informs what we know and how we think about abortion? How have narrative traditions created certain attitudes toward abortion that cover over things like misogyny and patriarchal control of women’s bodies? Why is abortion such a contentious issue? Is it personal? Should it be political? We will investigate these questions and more throughout the course.
Abortion has come to be a cornerstone of feminist discourse focused on bodily agency through reproductive health, rights, and justice. This course will briefly look at the history of abortion, as a form of women’s knowledge and the rhetoric surrounding it, before looking at contemporary feminist scholarship that covers everything from theology to medical and legal issues to safe, timely access to abortion services in Canada. It will also ask students to think about how framing abortion through feminism creates a feminist a worldview that can be challenging to navigate when other worldviews come into play. Since abortion has captured both our political and personal imaginations, part of the aim of the course is to untangle some of the difficulties intertwined through how we’ve inherited ideas, stories, and conversations about abortion.

Images of abortifacients from early modern medical texts.
Course Objectives
By coming to class prepared, curious, open-minded, and prepared to contribute to our classroom community, you will, by the end of the semester, achieve the learning objectives:
- Understand the range of feminist thought surrounding abortion
- Identify and draw from examples of strategies for approaching and engaging in ethical debates about abortion
- Engage your classmates (and their knowledge and skills, of course) in devising and carrying out a project, and, in turn, contribute your feedback and skills to their projects
- Read more thoughtfully, speak more confidently, and write more comfortably, in a variety of formats
- Better envision yourself as an empowered, effective feminist/activist: one who knows their strengths and weaknesses, and can assess and use available resources to contribute to the building of a better, more just, feminist world
Reading List
Articles/Chapters/Excerpts
- Bayles, Martha. “Feminism and Abortion.” The Atlantic, 265.4, 1990, pp. 79, 84-88.
- The Boston Woman’s Health Book Collective. Excerpts from Our Bodies, Ourselves, Atria Books, 2011.
- Christopoulos, John. Excerpts from “Introduction: The Meanings of Abortion” from Abortion in Early Modern Italy, Harvard UP, 2021, pp. 1-45.
- Colker, Ruth. “Feminism, Theology, and Abortion: Toward Love, Compassion, and Wisdom.” California Law Review, 77.5, 1989, pp. 1011-1075.
- Cornell, Drucilla. “Dismembered Selves and Wandering Wombs” from Left Legalism/Left Critique, edited by Janet Halley and Wendy Brown, Duke UP, 2022, pp. 337-72.
- Gilligan, Carol. Excerpts from In a Different Voice. 1982. Harvard UP, 2016.
- Goodwin, Michele. “Introduction” & “Abortion Law” from Policing the Womb: Invisible Women and the Criminalization of Motherhood, Cambridge UP, 2020, pp. 1-11, 46-77.
- Heyward, Carter. “Abortion: A Moral Choice.” Frontiers: A Journal of Women Studies, 9.1, 1986, pp. 42-45.
- Johnson, Barbara. “Apostrophe, Animation, and Abortion.” 1986. The Barbara Johnson Reader: The Surprise of Otherness, edited by Melissa González, et al., Duke UP, 2014, pp. 217-34.
- Kaplan, Laura. Excerpts from The Story of Jane, U of Chicago P, 1997.
- Little, Margaret Olivia. “Abortion, Intimacy, and the Duty to Gestate.” Ethical Theory and Moral Practice, 2.3, 1999, pp. 295-312.
- Markowitz, Sally. “Abortion and Feminism.” Social Theory and Practice, 16.1, 1990, pp. 1-17.
- O’Shaughnessy, Aideen Catherine. “On the Embodied Experience of Anti-Abortion Laws and Regulations: The Gendered Burden of ‘Abortion Work’.” Body and Society, 30.2, 2024, pp. 59-84.
- Petchesky, Rosalind Pollack. “Fetal Images: The Power of Visual Culture in the Politics of Reproduction.” Feminist Studies, 13.2, 1987, pp. 263-92.
- Poovey, Mary. “The Abortion Question and the Death of Man” from Feminists Theorize the Political, Routledge, 1992, pp. 239-56.
- Rowland, Allison. “Zoetropes: Turning Fetuses into Humans at the National Memorial for the Unborn.” Rhetorical Society Quarterly, 47.1, 2017, pp. 26-48.
- Schoen, Johanna. “Reconceiving Abortion: Medical Practice, Women’s Access, and Feminist Politics Before and After Roe v. Wade.” Feminist Studies, 26.2, 2000, pp. 349-76.
- Sharp, Jane. Excerpts from The Midwives Book, London, 1671.
- Sherwin, Susan. “Abortion Through a Feminist Ethics Lens.” Dialogue: Canadian Philosophical Review, 30.3, 1991, pp. 327-342.
- Smyth, John Ferdinand. Excerpt from A Tour in the United States of America, 1874.
- Squier, Susan. “Fetal Voices: Speaking for the Margins Within.” Tulsa Studies in Women’s Literature, 10.1, 1991, pp. 17-30.
- Stettner, Shannon, Kristin Burnett, and Travis Hay. “Introduction” from Abortion: History, Politics, and Reproductive Justice after Morgentaler, UBC Press, 2017.
- Summers, Montague, translator. Excerpts from Malleus Maleficarum, John Rodker, 1928.
- Tazi-Preve, Mariam Irene. “Unveiling Patriarchal Motherhood.” Canadian Woman Studies, 34.1/2, 2020, 163-73.
- Wiesner, Merry. “Early Modern Midwifery: A Case Study” from Women and Work in Preindustrial Europe, edited by Barbara Hanawalt, Indiana UP, 1986.
Media
- Phillips Smalley and Lois Weber. Where Are My Children? (1916)
- Jack Dabner. The Silent Scream (1984)
- Phyllis Nagy. Call Jane (2022)
- Rachel Cairns. Aborsh. https://www.aborsh.com
- https://www.ansirh.org/research/ongoing/turnaway-study
- https://www.actioncanadashr.org
- https://www.sistersong.net/reproductive-justice
- https://nafcanada.org
- https://www.arcc-cdac.ca
- https://www.canada.ca/en/public-health/services/sexual-health/abortion-canada.html
Assignments in the Course
To demonstrate your engagement in the course, knowledge of the material, and proficiency in the skills taught during the term, you will complete various assignments building toward your final creative project. Each assignment type is described below. Please pay close attention to due dates.
Grade Distribution
Critical Reflections 10%
Show-and-Tells 10%
Ally/Collaborator/Co-Conspirator Project 20%
Community Interviews 20%
Final Creative Project 20%
Attendance & Class Participation 20%
Critical Reflections – 10%
In this course we cover the difficult topic of abortion, that is both a public, politicized discourse and a very personal choice. The focus on the body and experience will be an important aspect of how we situate abortion in the course. These reflections give you the opportunity to process some of your affective responses to the readings and media, as well as critically engage with the rhetoric, language, and ideas.
These reflections can be about your personal experience, questions you might have, concerns, or how the week’s media and readings interact with other ideas and themes we’ve encountered. However, your writing must provide at least one citation (quote, summary, or paraphrase) to anchor your ideas. Your answers should be specific and detailed, even if they are not fully formed thoughts. Each reflection should be no more than one (1) page, double spaced.
Show-and-Tells – 10%
If you ever did “show-and-tell” in elementary school, you’re already familiar with this kind of sharing. Each student is asked to bring in an item for show and tell two (2) times during the semester: one before midterm and one after. Bring in whatever you’d like to share, as long as it has some connection to abortion. You might bring in a flyer from a protest, a vlog or blog, an article from a newspaper, a meme, a picture, or an advertisement… the possibilities are endless. The object can be anti-abortion, pro-abortion, or pro-choice. We will spend a few minutes at the beginning of each class doing show-and-tell before our discussion of the day’s readings and other materials. You’ll be asked to introduce the object and explain why it made you think of the class and share any questions or ideas it may have provoked.
Ally/Collaborator/Co-Conspirator Project – 20%
This assignment gives you an opportunity to find resources in the community to help support access to abortion. With a partner or small group, you will create an archive of materials about abortion access in Saskatchewan. You might include photography, pamphlets, event posters, brochures, stories, or other resources that create awareness surrounding abortion. Part of the project will investigate some of the challenges and barriers to access, while the second part will be a reflection on what it means to advocate for safe, timely access to abortion in a Canadian context.
Community Interviews – 20%
Abortion is rarely a choice made in a vacuum. Instead, it’s deeply relational. This is your opportunity to find out more about the experience of abortion in your community. You can interview family, friends, fellow students, or abortion access providers. For this project you’ll need to create a proposal that includes who you might interview, ethical guidelines for how to approach interviewees, and what questions you would like to focus on as part of the “conversation starter.” Interviews can be recorded, with appropriate permissions, or transcribed for the course. There will be a reflection component to this assignment, that asks you to consider what you learned about abortion in your community of choice.
Final Creative Project – 20%
This creative project gives students a chance to respond to the course’s content in a variety of ways. At the end of the course, students will be asked to submit a proposal on the kind of creative project they would like to submit. It may be an artwork, a photo journal, scrapbook, illustration, podcast, vlog, op-ed, creative non-fiction essay, or any other type of creative project that focuses on some aspect of abortion discussed in the course. The project should have a 2 to 3 page critical introduction that cites material from the course and includes a reflection on what abortion means to the student and as a wider political issue.
Attendance & Class Participation – 20%
Participation marks depend on the student’s attendance but also their engagement in class. On the first day, we will collaborative draw up an agreement for what “counts” as participation. This might include contributing to class discussion and group work, or other forms of participation that adapt to the students’ learning needs and abilities.
Course Schedule
Week 1 – Introductions and Historical Artifacts of Abortion
- First Day of Class: general overview, contract on respect in the classroom, what counts as participation, and discussion about abortion
- Readings
- Sharp, excerpts from The Midwives Book
- Smyth, excerpt from A Tour in the United States of America
- Wiesner, “Early Modern Midwifery: A Case Study”
- Assignments Due: Critical reflection on the history of abortion #1
Week 2 – Abortion and Morality
- Readings
- Christopoulos, “Introduction: The Meanings of Abortion
- Summers, excerpts from Malleus Maleficarum
- Heyward, “Abortion: A Moral Choice”
- In-class Screening
- Phillips Smalley and Lois Weber. Where Are My Children? (1916)
- Assignments Due: Critical reflection on the history of abortion #2
Week 3 – Representations and Images
- Readings
- Gilligan, excerpts from In a Different Voice
- Johnson, “Apostrophe, Animation, and Abortion”
- In-class Screening
- Jack Dabner. The Silent Scream (1984)
- Assignments Due: Critical reflection on the representation of abortion #3
Week 4 – Abortion in Canada
- City Tour of Abortion Resources
- Media
Week 5 – Abortion in Canada
- Media
- Aborsh, season 1
- Assignments: Critical reflection on abortion in Canada
Week 6 – Abortion in Canada
- Media
- Aborsh, season 2
- Assignments: Ally/Collaborator/Co-Conspirator Projects
Week 7 – Abortion and Ethics
- Readings
- Petchesky, “Fetal Images”Sherwin, “Abortion Through a Feminist Ethics Lens”
- Squier, “Fetal Voices: Speaking for the Margins Within”
- Assignments Due: Critical reflection on the ethics of abortion
Week 8 – The Jane Collective
- Readings
- Kaplan, excerpts from The Story of Jane
- In-class Screening
- Phyllis Nagy. Call Jane (2022)
- Assignments: Critical reflection on the Jane Collective
Week 9 – The Connection between Abortion and Feminism
- Readings
- Markowitz, “Abortion and Feminism”
- Colker, “Feminism, Theology, and Abortion”
- Bayles, Martha. “Feminism and Abortion.”
- Excerpts from Our Bodies, Ourselves
- Assignments: Critical reflection on reproductive justice and feminism
Week 10 – Thinking about Legality
- Readings
- Little, “Abortion, Intimacy, and the Duty to Gestate
- O’Shaughnessy, “On the Embodied Experience of Anti-Abortion Laws and Regulations”
- Goodwin, “Introduction” & “Abortion Law”
- Assignments: Community Interviews
Week 11 – Rhetoric and Embodiment
- Readings
- Cornell, “Dismembered Selves and Wandering Wombs”Rowland, “Zoetropes”
- Poovey, “The Abortion Question and the Death of Man”
- Assignments: Critical reflection on the rhetoric used to imagine abortion
Week 12 – Abortion and Contemporary Feminist Thought
- Readings
- Schoen, “Reconceiving Abortion”
- Stettner, Burnett, and Hay, “Introduction”
- Tazi-Preve, “Unveiling Patriarchal Motherhood”
- Assignments: Final Creative Project
Women’s & Gender Studies / Feminist Philosophy (honours / graduate course)

Course Description
The focus of this course is to introduce interdisciplinary, multi-faceted areas of feminist representation. The course aims to expose students to the long history of feminist thinking that forms the foundations of contemporary feminist thought. We will examine how feminists write about the condition of women, complicating the categorizing tendency, as well as focus not only on what they say but on how they pursue their critiques. In responding to historical accounts of women authored by men, we will examine how feminist theorists have challenged assertions, assumptions, and omissions using writing, voice, and experience as a tool for activism.
While this course is not exhaustive, we will consider historical writings that analyse the diversity of feminist approaches to issues of race, culture, sexuality, class, ability, privilege and disadvantage. We will also look at how feminism proposes an overarching interactional framework for thinking about equity and inclusion, at the same time it contends with some of its exclusionary skeletons in its metaphorical closet. We’ll follow a general chronology of texts except when there’s a direct “clap-back” so that we can explore the exchange of ideas.
Reading List
- 1405. De Pizan, excerpts from The Book of the City of Ladies
- 1792. Wollstonecraft, excerpts from The Vindication of the Rights of Women
- 1848. Cady Stanton, “Declaration of Sentiments”
- 1851. Truth, “Ain’t I A Woman?
- 1851. Taylor, “Enfranchisement of Women”
- 1869. Mill (& Mill), excerpts from The Subjection of Women
- 1871. Butler, “Letter to My Countrywomen”
- 1872. Anthony, “Speech after Arrest for Illegal Voting”
- 1882. Douglass, excerpts from The Life and Times of Frederick Douglass
- 1884. Engels, excerpts from The Origins of the Family, Private Property and the State
- 1892. Stanton, “Solitude of Self”
- 1898. Gilman, excerpts from Women and Economics
- 1910. Goldman, “The Traffic in Women”
- 1913. Wright, “Letter on Militant Hysteria”
- 1920. Freud, “The Psychogenesis of a Case of Homosexuality in a Woman”
- 1922. Horney, “On the Genesis of the Castration Complex in Women”
- 1922. Freud, “Medusa’s Head”
- 1923. Browne, “Studies in Feminine Inversion”
- 1929. Riviére, “Womanliness as a Masquerade”
- 1929. Woolf, excerpts from A Room of One’s Own
- 1931. Freud, “Female Sexuality”
- 1932. Horney, “The Dread of Woman”
- 1934. Horney, “The Overvaluation of Love”
- 1938. Woolf, excerpts from Three Guineas
- 1949. De Beauvoir, excerpts from The Second Sex
- 1953. James, “A Woman’s Place”
- 1963. Friedan, excerpts from The Feminine Mystique
- 1968. Joreen, “The BITCH Manifesto”
- 1969. Millett, excerpts from Sexual Politics
- 1970. Firestone, excerpts from The Dialectic of Sex
- 1970. Koedt, “The Myth of the Vaginal Orgasm”
- 1970. Radicalesbians, “The Woman-Identified Woman”
- 1974. Ortner, “Is Female to Male as Nature Is to Culture?”
- 1975. Cixous, “The Laugh of the Medusa”
- 1975. Lakoff, excerpts from Language and a Woman’s Place
- 1975. Rubin, “The Traffic in Women: Notes on the ‘Political Economy’ of Sex”
- 1975. Delphy, “For a Materialist Feminism”
- 1977. Irigaray, excerpts from This Sex Which Is Not One
- 1978. Lorde, “Age, Race, Class, and Sex: Women Redefining Difference”
- 1978. Wittig, “The Straight Mind”
- 1981. Hartmann, “The Unhappy Marriage of Marxism and Feminism”
- 2000. hooks, “Feminism Is for Everybody”
While this reading list looks intimidating, many of the readings have been abridged and will be available online through the course page. The expectation is that students should spend 2-3 hours a week preparing for each week’s in-class content.
Assignments in the Course
To demonstrate your engagement in the course, knowledge of the material, and proficiency in the skills taught during the term, you will complete various assignments building toward your final essay. Each assignment type is described below. Please pay close attention to due dates.
Grade Distribution
- Midterm Exam #1 20%
- Midterm Exam #2 20%
- Feminist History Scrapbook/Poster 20%
- Final Synthesis Paper 25%
- Attendance & Class Participation 15%
Midterm Exams – 40% (2 x 20%)
These midterm exams will consist of multiple choice and short answer questions to gauge your knowledge retention in the course—do you remember who said what? And when? Why might this matter? A portion of the exam will be about rote memory, while the remainder will be about students’ engagement with feminist themes and representational strategies covered so far in the course.
Feminist History Scrapbook/Poster – 20%
This creative project allows students to choose a feminist representational strategy that has emerged in the course and respond to it. The scrap book should demonstrate a clear understanding of the connections between thinkers and ideas curated by the student and have a visual component. The student might find historical images, create a timeline of memes, produce something with their own artistic twist, or include a range of found objects that, in some way, reflect the feminist representational strategy focusing the project.
Final Synthesis Paper – 25%
We end the semester in the 1970s-80s thinking about the future of feminist thought. This paper will be an accumulative look at the history of feminism covered in the course. Students will need to consider 8-10 readings in depth, addressing the historical moment in which they were produced, how the ideas contributed to feminist thought, and what are some of the concerns that grew out of the writings.
The essay should be 15-20 pages, double spaced, and include a small amount (2-5 sources) of independent research to help students contextualize the historical readings.
Attendance & Class Participation – 15%
Participation marks depend on the student’s attendance but also their engagement in class. On the first day, we will collaborative draw up an agreement for what “counts” as participation. This might include contributing to class discussion and group work, or other forms of participation that adapt to the students’ learning needs and abilities.
Course Schedule
Week 1 – Feminism Is for Everybody
- Readings
- hooks, “Feminism Is for Everybody”
- De Pizan, excerpts from The Book of the City of Ladies
Week 2 – Early Feminist Conversations
- Readings
- Wollstonecraft, excerpts from The Vindication of the Rights of Women
- Cady Stanton, “Declaration of Sentiments”
- Truth, “Ain’t I A Woman?
- Taylor, “Enfranchisement of Women”
Week 3 – Subjection and Rights
- Readings
- Mill (& Mill), excerpts from The Subjection of Women
- Butler, “Letter to My Countrywomen”
- Anthony, “Speech after Arrest for Illegal Voting”
- Douglass, excerpts from The Life and Times of Frederick Douglass
- Stanton, “Solitude of Self”
- Goldman, “The Traffic in Women”
Week 4 – Marxism
- Readings
- Engels, excerpts from The Origins of the Family
- Gilman, excerpts from Women and Economics
- Hartmann, “The Unhappy Marriage of Marxism and Feminism”
- Midterm Exam #1
Week 5 – Contending with Freud’s Legacies
- Readings
- Freud, “The Psychogenesis of a Case of Homosexuality in a Woman”
- Horney, “On the Genesis of the Castration Complex in Women
- Browne, “Studies in Feminine Inversion”
- Wright, “Letter on Militant Hysteria”
- Freud, “Female Sexuality”
Week 6 – Still Not Happy with Freud
- Readings
- Horney, “The Dread of Woman”
- Horney, “The Overvaluation of Love”
- Riviére, “Womanliness as a Masquerade”
- Freud, “Medusa’s Head”
- Cixous, “The Laugh of the Medusa”
Week 7 – Woolf’s Legacy
- Readings
- Woolf, excerpts from A Room of One’s Own
- Woolf, excerpts from Three Guineas
- Midterm Exam #2
Week 8 – Changing the Philosophical Landscape
- Readings
- De Beauvoir, excerpts from The Second Sex
- James, “A Woman’s Place”
Week 9 – Public/Private Politics
- Readings
- Friedan, excerpts from The Feminine Mystique
- Joreen, “The BITCH Manifesto”
- Millett, excerpts from Sexual Politics
Week 10 – The 1970s and “Radical” Feminism
- Readings
- Firestone, excerpts from The Dialectic of Sex
- Koedt, “The Myth of the Vaginal Orgasm”
- Radicalesbians, “The Woman-Identified Woman”
- Feminist History Scrapbook/Poster Due
Week 11 – Language and Materiality
- Readings
- Ortner, “Is Female to Male as Nature Is to Culture?”
- Lakoff, excerpts from Language and a Woman’s Place
- Rubin, “The Traffic in Women: Notes on the ‘Political Economy’ of Sex”
- Delphy, “For a Materialist Feminism”
Week 12 – A Mixed Bag: Looking Towards an Intersectional Future
- Readings
- Irigaray, excerpts from This Sex Which Is Not One
- Lorde, “Age, Race, Class, and Sex: Women Redefining Difference”
- Wittig, “The Straight Mind”
- Final Synthesis Essay Due
reading response & student posters






